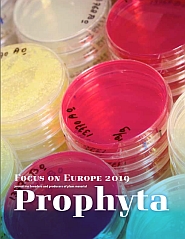

Prophyta - Journal for breeders and producers of plant material
Prophyta is a renowned journal with a long-standing reputation. For many decades, its editorial team has focused on significant stories from the fields of breeding and propagation. The journal targets influencers, researchers, and professionals working in the seed and propagation business, offering relevant and thought-provoking articles on the breeding and propagation of vegetable and fruit crops, ornamentals, trees and agricultural crops. It also provides background information on the seed and plant propagation sectors, including technological and scientific developments. Prophyta is published twice a year.